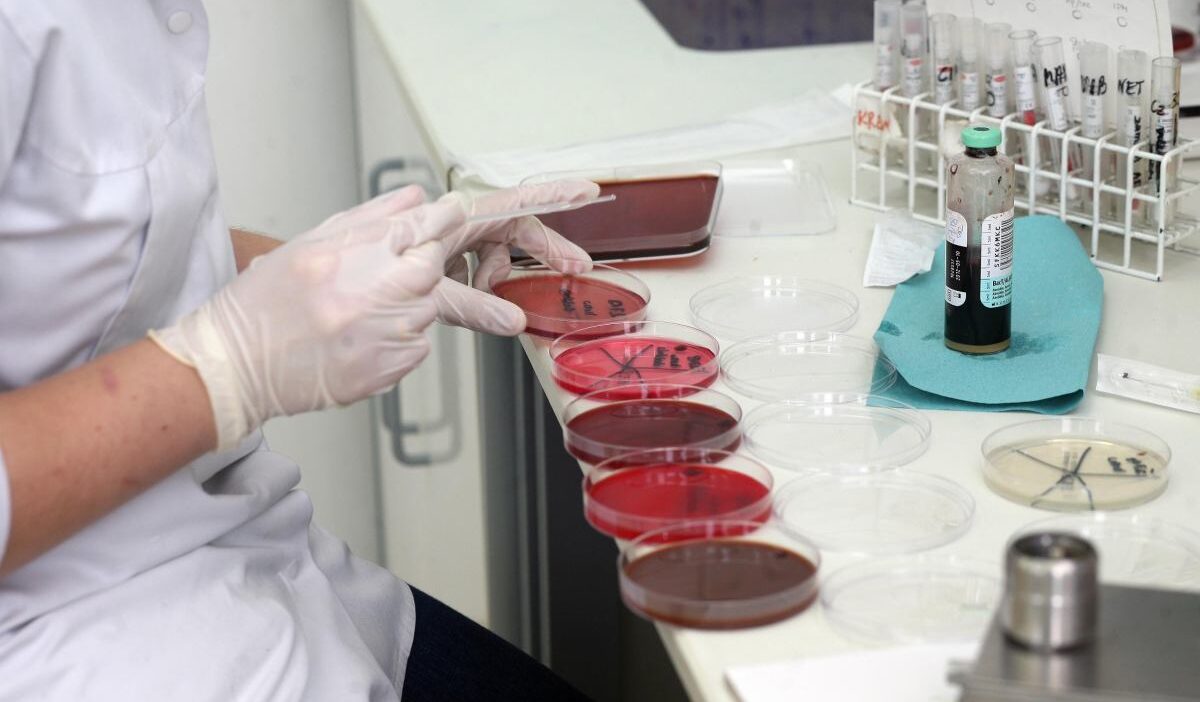
Brezilya'da yüksek güvenlikli laboratuvardan virüs örnekleri kayboldu, zanlı gözaltına alındı 1 Brezilya da yuksek guvenlikli laboratuvardan virus ornekleri kayboldu zanli gozaltina alindi 56718

Brezilya’daki bir laboratuvardan Şubat ayında kaybolan virüs örnekleri ile ilgili soruşturma kapsamında 36 yaşındaki Soledad Palameta M. gözaltına alındı. Üçüncü güvenlik seviyesine sahip laboratuvardan kaybolan örnekler arasında H1N1 ve H3N2 gibi grip virüslerinin de bulunduğu belirtiliyor. Üniversite, olayla ilgili gerekli tüm adımları attığını ve yetkililerle işbirliği yaptığını açıkladı.
Laboratuvardan Kayıp Bildirimi Haftalar Sonra Yapıldı
Üniversite yetkilileri, laboratuvardan araştırma materyallerinin çalındığına dair bilgiyi Şubat ayında aldıklarını ancak resmi açıklamayı bu hafta yaptıklarını belirtti. Açıklamada, rektörlük bürosunun durumu öğrenir öğrenmez polis ve Ulusal Sağlık Denetleme Ajansı ile irtibata geçerek gerekli soruşturma ve uzman incelemelerinin başlatılması için harekete geçtiği ifade edildi.
Yüksek Güvenlikli Laboratuvarın Önemi
Virüs ve bakterilerin çalındığı laboratuvar, üçüncü seviye biyolojik güvenlik seviyesine sahip. Bu, laboratuvarda ciddi hastalıklara neden olabilen ve damlacık yoluyla bulaşan virüs ve bakteriler üzerinde araştırmalar yürütülebileceği anlamına geliyor. Ebola virüsü gibi en tehlikeli patojenler ise dördüncü seviye güvenlik gerektiriyor.
Üniversitenin Açıklaması ve Soruşturma
Üniversite tarafından yapılan açıklamada, “Üniversite gerekli tüm önlemleri almış ve ilgili makamlarla tam işbirliği içinde. Olayla bağlantısı olabilecek kişiler, yürürlükteki yasalara uygun olarak sorumlu tutulacaktır.” denildi.
Polis Operasyonu ve Ele Geçirilen Örnekler
Polis, yaptığı aramalarda kayıp materyalleri ele geçirdi ve 36 yaşındaki bir kadını gözaltına aldı. Ele geçirilen materyaller Tarım ve Hayvancılık Bakanlığı’na gönderildi. Bakanlık, materyallerin içeriği hakkında herhangi bir bilgi vermedi. Brezilya’daki g1 haber portalına göre, ele geçirilen materyaller arasında H1N1 ve H3N2 grip virüsü türleri ile insanları ve domuzları etkileyen diğer virüsler bulunuyordu.
Gözaltına Alınan Şüpheli ve Soruşturmanın Detayları
Polis, 23 Mart Pazartesi günü virüsleri çaldığı iddia edilen 36 yaşındaki Soledad Palameta M.’yi gözaltına aldı. Palameta M., Unicamp Üniversitesi Biyoloji Enstitüsü’nde bakteri, virüs ve gıda güvenliği alanlarında uzman bir araştırmacı. Medyada yer alan haberlere göre, Palameta M. gözaltına alındıktan sonra serbest bırakıldı ve yargılanmak üzere serbest bırakıldı. Araştırmacının avukatı G1’e yaptığı açıklamada, suçlamayı destekleyecek herhangi bir kanıt bulunmadığını belirtti.
Araştırmacının Eşi de Şüpheli Listesinde
Araştırmacının eşi Michael Edward M.’nin de olayla ilgili şüpheli olduğu belirtiliyor. Michael Edward M., aynı üniversitede veterinerlik alanında doktora yapıyor. Campinas Federal Polisi yaptığı açıklamada, “Şüpheliler, nitelikli hırsızlık, usulsüzlük ve genetik olarak modifiye edilmiş bir organizmanın yasa dışı taşınması suçlarından, görevleri çerçevesinde sorumlu tutulacaklardır.” ifadelerine yer verdi.
Kaynak : Gazeta